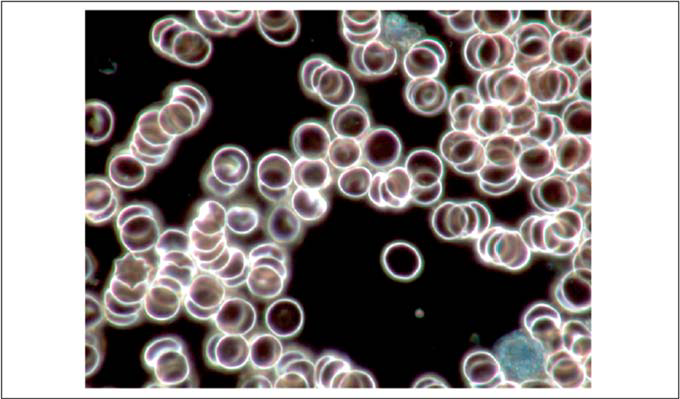

Предисловие редактора: для своей курсовой работы по курсу «Биология» в гимназии Рабанус-Маурус в город Майнц, Кира Фидермутц исследовала проблему «Экспериментальные исследования живой крови методами темнопольной микроскопии». Она изучила влияние продуктов питания и никотина на состояние крови, используя методы темнопольной микроскопии для пояснения полученных результатов. Мы публикуем ее работу в сокращенном виде.
1. Базовые принципы
1.1 Функции крови
1. Базовые принципы
1.1 Функции крови
Самая важная задача крови – переносить различные вещества. Таким образом, вода и питательные вещества посредством крови попадают из органов пищеварения и мест хранения в ткани, побочные продукты попадают к органам выведения, а гормоны и другие вещества-проводники попадают к соответствующим органам или клеткам. Кроме того, в организме благодаря крови происходит распределение кислорода и углекислого газа через органы дыхательной системы к тканям или наоборот. Регуляция температуры тела также происходит при помощи крови, так как тепло достигает поверхности тела, откуда оно и выделяется.
Функции непосредственно самой крови включают в себя коагуляцию, что служит для залечивания ран и выполняет буферную функцию, для того чтобы поддерживать постоянные физико-химические условия в организме, например, уровень pH и ионный баланс. Кроме этого, функция кровь выполняет и защитную функцию. В крови образуются антитела и фагоциты, обеспечивая защиту от воздействия патогенных микробов, токсинов и инородных веществ.
Функции непосредственно самой крови включают в себя коагуляцию, что служит для залечивания ран и выполняет буферную функцию, для того чтобы поддерживать постоянные физико-химические условия в организме, например, уровень pH и ионный баланс. Кроме этого, функция кровь выполняет и защитную функцию. В крови образуются антитела и фагоциты, обеспечивая защиту от воздействия патогенных микробов, токсинов и инородных веществ.

Рисунок 1: Зависимость относительной вязкости крови от уровня гематокрита, согласно Guyton
1.2 Влияние курения на гемореологические факторы
Различные исследования подтверждают, что курение сигарет оказывает отрицательное влияние на физические свойства крови и на ее свертываемость (Belch 1984; Daibianco 1989; Feher 1990; Gudmumdsson & Bjelle 1993).
При курении, в организм поступает большое количество угарного газа (СО), при вдыхании угарный газ связывается с гемоглобином в крови, а не с кислородом (О2). В результате этого, ткани получают намного меньше кислорода. Все это может стать причиной развития гипоксии тканей, так как мозг посылает сигнал костному мозгу производить еще больше эритроцитов.
В результате, повышается уровень карбоксигемоглобина (связывание СО с гемоглобином) в крови, и автор Sagone считает, что это также является причиной развития гипоксии; Anadere полагает, что именно скопление эритроцитов приводит к гипоксии.
Последствия этих процессов таковы, что отмечается повышение гематокритного числа (то есть, количества кровяных клеток в крови), и повышается вязкость крови. Кроме того, ограничивается способность эритроцитов формироваться в крови, что приводит к их разрушению (Leonhardt) и оказывает негативное влияние на поставку кислорода (Salbas, 1994).
Вязкость крови непосредственно связана с содержанием воды, количеством эритроцитов, их способностью формироваться в организме, гематокритным числом (см. Рис. 1), температурой и, в меньшей степени, количеством белка в плазме.
У курильщиков вязкость крови повышена.
Одно из отличительных свойств эритроцитов – их способность объединяться вместе, как стопка момент (образование монетных столбиков или псевдоагглютинация), что отчетливо видно на темнопольном микроскопе.
Так как вязкость крови повышается, вместе с этим увеличивается и количество лейкоцитов (Blann 1992; Calori 1996; Thomas 1996), а также наблюдается тенденция к скоплению тромбоцитов (Pittilo 1984), то есть происходит развитие тромбов, так как пластины становятся все более вязкими. Повышается и вязкость плазмы, что связано не только со скоплением тромбоцитов, но также с повышенным уровнем фибриногена, вызванным курением. Молекула белка с длинной цепью способна строить своего рода мостики.В связи с тем, что молекула связывается с эритроцитами, белок может негативно повлиять на вязкость крови.
Проводя исследование на темнопольном микроскопе, мы можем увидеть все эти последствия: скопление тромбоцитов, повышенная вязкость в форме нитей фибрина, образующих своего рода сеть. Переход фибриногена в фибрин, его активную форму, указывает на повышенную активность факторов свертывания крови, в результате чего кровь становится комковатая.
1.3 Пищеварительный лейкоцитоз
Под термином «пищеварительный лейкоцитоз» мы понимаем повышение числа лейкоцитов после употребления пищи. Впервые этот феномен был выявлен Рудольфом Вирховом в 19 веке. Пока еще точно неизвестно, является ли это иммунным ответом на наличие чужеродного белка в пище или физиологической реакцией на высокое содержание жира.
После приема пищи с высоким содержанием белка, то есть после употребления мяса, пищеварительный лейкоцитоз значительно выше, чем после приема сырых продуктов. Таким образом, следует вывод, что физические свойства крови намного лучше у человека, который соблюдает принципы сыроедения, то есть употребляет пищу в ее природном состоянии, а именно, необработанные продукты.
Изучая кровь при помощи темнопольной микроскопии, я предприняла попытку показать влияние курения и диеты на состояние крови человека.
1.4.1 Исследование живой крови методами темнопольной микроскопии
Благодаря темнопольной микроскопии у нас есть возможность исследовать прозрачные вещества и вещества, не имеющие контраста без предварительного окрашивания. Мы можем также наблюдать за живыми веществами.
Среди всех компонентов крови, мы можем отдельно изучать эритроциты, тромбоциты, лейкоциты и лимфоциты. Броуновское движение частиц белка в результате повышения температуры крови также видно на темнопольном микроскопе.
1.4.2 Принцип работы темнопольной микроскопии
Простой пример из мира природы поможет нам лучше понять принцип работы темнопольного микроскопа. Если посмотреть на сети паука на ярком свету, то мы практически ничего не увидим. Однако, если посмотреть на сеть с другого угла так, чтобы свет падал на сеть, находящуюся на темном фоне, то мы сможем рассмотреть все очень четко.
Именно этот феномен, когда некоторые предметы становятся видимыми только на темном фоне применим также и к работе темнопольного микроскопа.
Под термином «пищеварительный лейкоцитоз» мы понимаем повышение числа лейкоцитов после употребления пищи. Впервые этот феномен был выявлен Рудольфом Вирховом в 19 веке. Пока еще точно неизвестно, является ли это иммунным ответом на наличие чужеродного белка в пище или физиологической реакцией на высокое содержание жира.
После приема пищи с высоким содержанием белка, то есть после употребления мяса, пищеварительный лейкоцитоз значительно выше, чем после приема сырых продуктов. Таким образом, следует вывод, что физические свойства крови намного лучше у человека, который соблюдает принципы сыроедения, то есть употребляет пищу в ее природном состоянии, а именно, необработанные продукты.
Изучая кровь при помощи темнопольной микроскопии, я предприняла попытку показать влияние курения и диеты на состояние крови человека.
1.4.1 Исследование живой крови методами темнопольной микроскопии
Благодаря темнопольной микроскопии у нас есть возможность исследовать прозрачные вещества и вещества, не имеющие контраста без предварительного окрашивания. Мы можем также наблюдать за живыми веществами.
Среди всех компонентов крови, мы можем отдельно изучать эритроциты, тромбоциты, лейкоциты и лимфоциты. Броуновское движение частиц белка в результате повышения температуры крови также видно на темнопольном микроскопе.
1.4.2 Принцип работы темнопольной микроскопии
Простой пример из мира природы поможет нам лучше понять принцип работы темнопольного микроскопа. Если посмотреть на сети паука на ярком свету, то мы практически ничего не увидим. Однако, если посмотреть на сеть с другого угла так, чтобы свет падал на сеть, находящуюся на темном фоне, то мы сможем рассмотреть все очень четко.
Именно этот феномен, когда некоторые предметы становятся видимыми только на темном фоне применим также и к работе темнопольного микроскопа.

2. Эксперименты
2.1 Процедура исследования крови
2.1.1 Сравнение крови курящих и некурящих
В нашем исследовании приняли участие 4 курящих и 4 некурящих человека.
Утром я взяла образцы крови участников натощак. Эти образцы были необходимы для сравнения. Перед забором крови участникам разрешалось только пить воду.
Сначала мы взяли образцы крови у курильщиков в 8 часов утра. Сразу же после этого, участники выкурили по 1 сигарете. Через 15 минут мы взяли еще один образец крови. Около 5 часов вечера был взят последний образец крови, при этом участники уже выкурили разное количество сигарет. Испытуемых также попросили вести учет количества выкуренных сигарет в период с 08.15 до 17.00 часов.
2.1.2 Эксперимент 2: сравнение употребления сырых фруктов и овощей и мяса
В данном эксперименте приняли участие три некурящих человека, чтобы избежать искажения результатов, вызванного курением.
Сначала в 8 часов утра образцы крови натощак были взяты для проведения сравнения.
В день сыроедения участники исследования ели сырые фрукты на завтрак, такие как яблоки, груши, мандарины, апельсины и бананы; затем на ланч они ели салат из помидор, огурцов и моркови. Допускалось употребление таких напитков как вода, чай и сок. В 4 часа вечера были взяты образцы крови.
На следующий день мы проверяли участников после того, как они употребляли мясо. Утром им был предложен куриный суп, на обед – половина цыпленка-гриль без гарнира. Для сравнения одному из участников была предложена свинина, вместо курицы.
Спустя час после обеда у испытуемых была взята кровь. Образцы крови изучили на темнопольном микроскопе и сравнили результаты при помощи цифровых снимков.
Оба эксперимента проводились три раза, чтобы получить статистически значимый вывод.
Рисунок 1: Испытуемый E, курящий, после воздержания от сигареты; (увеличение х1000) 20.01.08


Рисунок 2: Испытуемый Е, курящий, после 1 сигареты, анализ 2; (увеличение х1000), 02.02.08; скопление тромбоцитов



